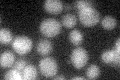
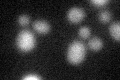

View description
Component of the TOM (translocase of outer membrane) complex responsible for recognition and initial import steps for all mitochondrially directed proteins; acts as a receptor for incoming precursor proteins
Localization:
Intensity:
Fold change:
Significance:
-
C’ GFP library in SD
below threshold16.96 -
N' NOP1pr-GFP in SD

N/A0 -
N' TEF2pr-mCherry in SD

N/A0 -
N' NATIVEpr-GFP in SD

N/A0 -
N' TEF2pr-VC and Cyto-VN in SD

N/A0 -
C’ GFP library in SD+DTT
cytosol14.910.87No -
C’ GFP library in SD+H2O2

cytosol13.290.78No -
C’ GFP library in Starvation Media

cytosol14.980.88No -
C’ GFP library on the background of Pup2-DaMP

below threshold -
C’ GFP library on the background of CCT mutant

below threshold14.89440.877612No
